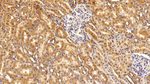
Interferon alpha-2 Antibody in Immunohistochemistry (Paraffin) (IHC (P))

Search
Invitrogen
Interferon alpha-2 Polyclonal Antibody
{{$productOrderCtrl.translations['antibody.pdp.commerceCard.promotion.promotions']}}
{{$productOrderCtrl.translations['antibody.pdp.commerceCard.promotion.viewpromo']}}
{{$productOrderCtrl.translations['antibody.pdp.commerceCard.promotion.promocode']}}: {{promo.promoCode}} {{promo.promoTitle}} {{promo.promoDescription}}. {{$productOrderCtrl.translations['antibody.pdp.commerceCard.promotion.learnmore']}}
图: 1 / 4
Interferon alpha-2 Antibody (PA5149928) in IHC (P)

Please note: We are reviewing Western blot images included in the antibody testing data in our catalog, including those provided by third parties. Unless expressly labeled or annotated as “raw-unedited”, Western blot images included in the antibody testing data in our catalog may have been edited, optimized or otherwise adjusted for presentation.
产品信息
PA5149928
种属反应
宿主/亚型
分类
类型
抗原
偶联物
形式
浓度
规格
纯化类型
保存液
内含物
保存条件
运输条件
RRID
靶标信息
IFN alpha (Interferon alpha) is a Type I interferon belonging to a family of structurally related, species-specific proteins exclusive to vertebrates. The interaction of IFN-alpha with its receptor component result in the activation of a number of signaling pathways which are mainly involved in innate immune response against viral infection. In humans, the gene for IFN alpha is located on on chromosome 9. The type I interferons consist of 14 different alpha isoforms (subtypes with slightly different specificities), and single beta, omega, epsilon and kappa isoforms. Homologous molecules are found in many species, including rats and mice (and most mammals), and have been identified in birds, reptiles and fish species. IFN alpha is produced primarily by plasmacytoid dendritic cells, is a potent component of the anti-viral innate immune response and modulates adaptive immunity. Diseases associated with the dysfunction of IFN alpha include Hepatitis C and Hepatitis.
仅用于科研。不用于诊断过程。未经明确授权不得转售。
篇参考文献 (0)
生物信息学
蛋白别名: IFN-a; IFN-alpha 1b; IFN-alpha-1/13; IFN-alpha-2; IFNA 2; Interferon; interferon alpha 1b; interferon alpha family, gene 2; Interferon alpha-2; Interferon alpha-A; interferon alpha-D; Interferon-alpha II; LeIF A; leIF D; RP11-354P17.2
基因别名: IFNA2; IFNA2A; IFNA2B; IFNA2C
Entrez Gene ID: (Rat) 298213




